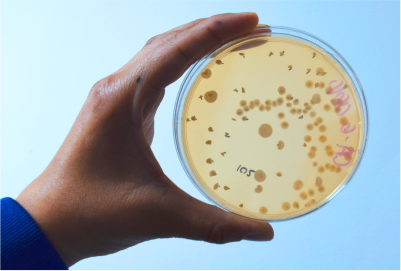
www.tecmolfarmaceutica.com Control calidad

CONTROL CALIDAD
Las áreas cuentan con sistemas de apoyo crítico de agua y aire acondicionado/controlado.
La infraestructura y los equipos están bajo delineamientos en BPL/GLP.
Se cuenta con personal idóneo y capacitado en cada área como: microbiólogos, químicos, químicos farmacéuticos y toxicólogos.